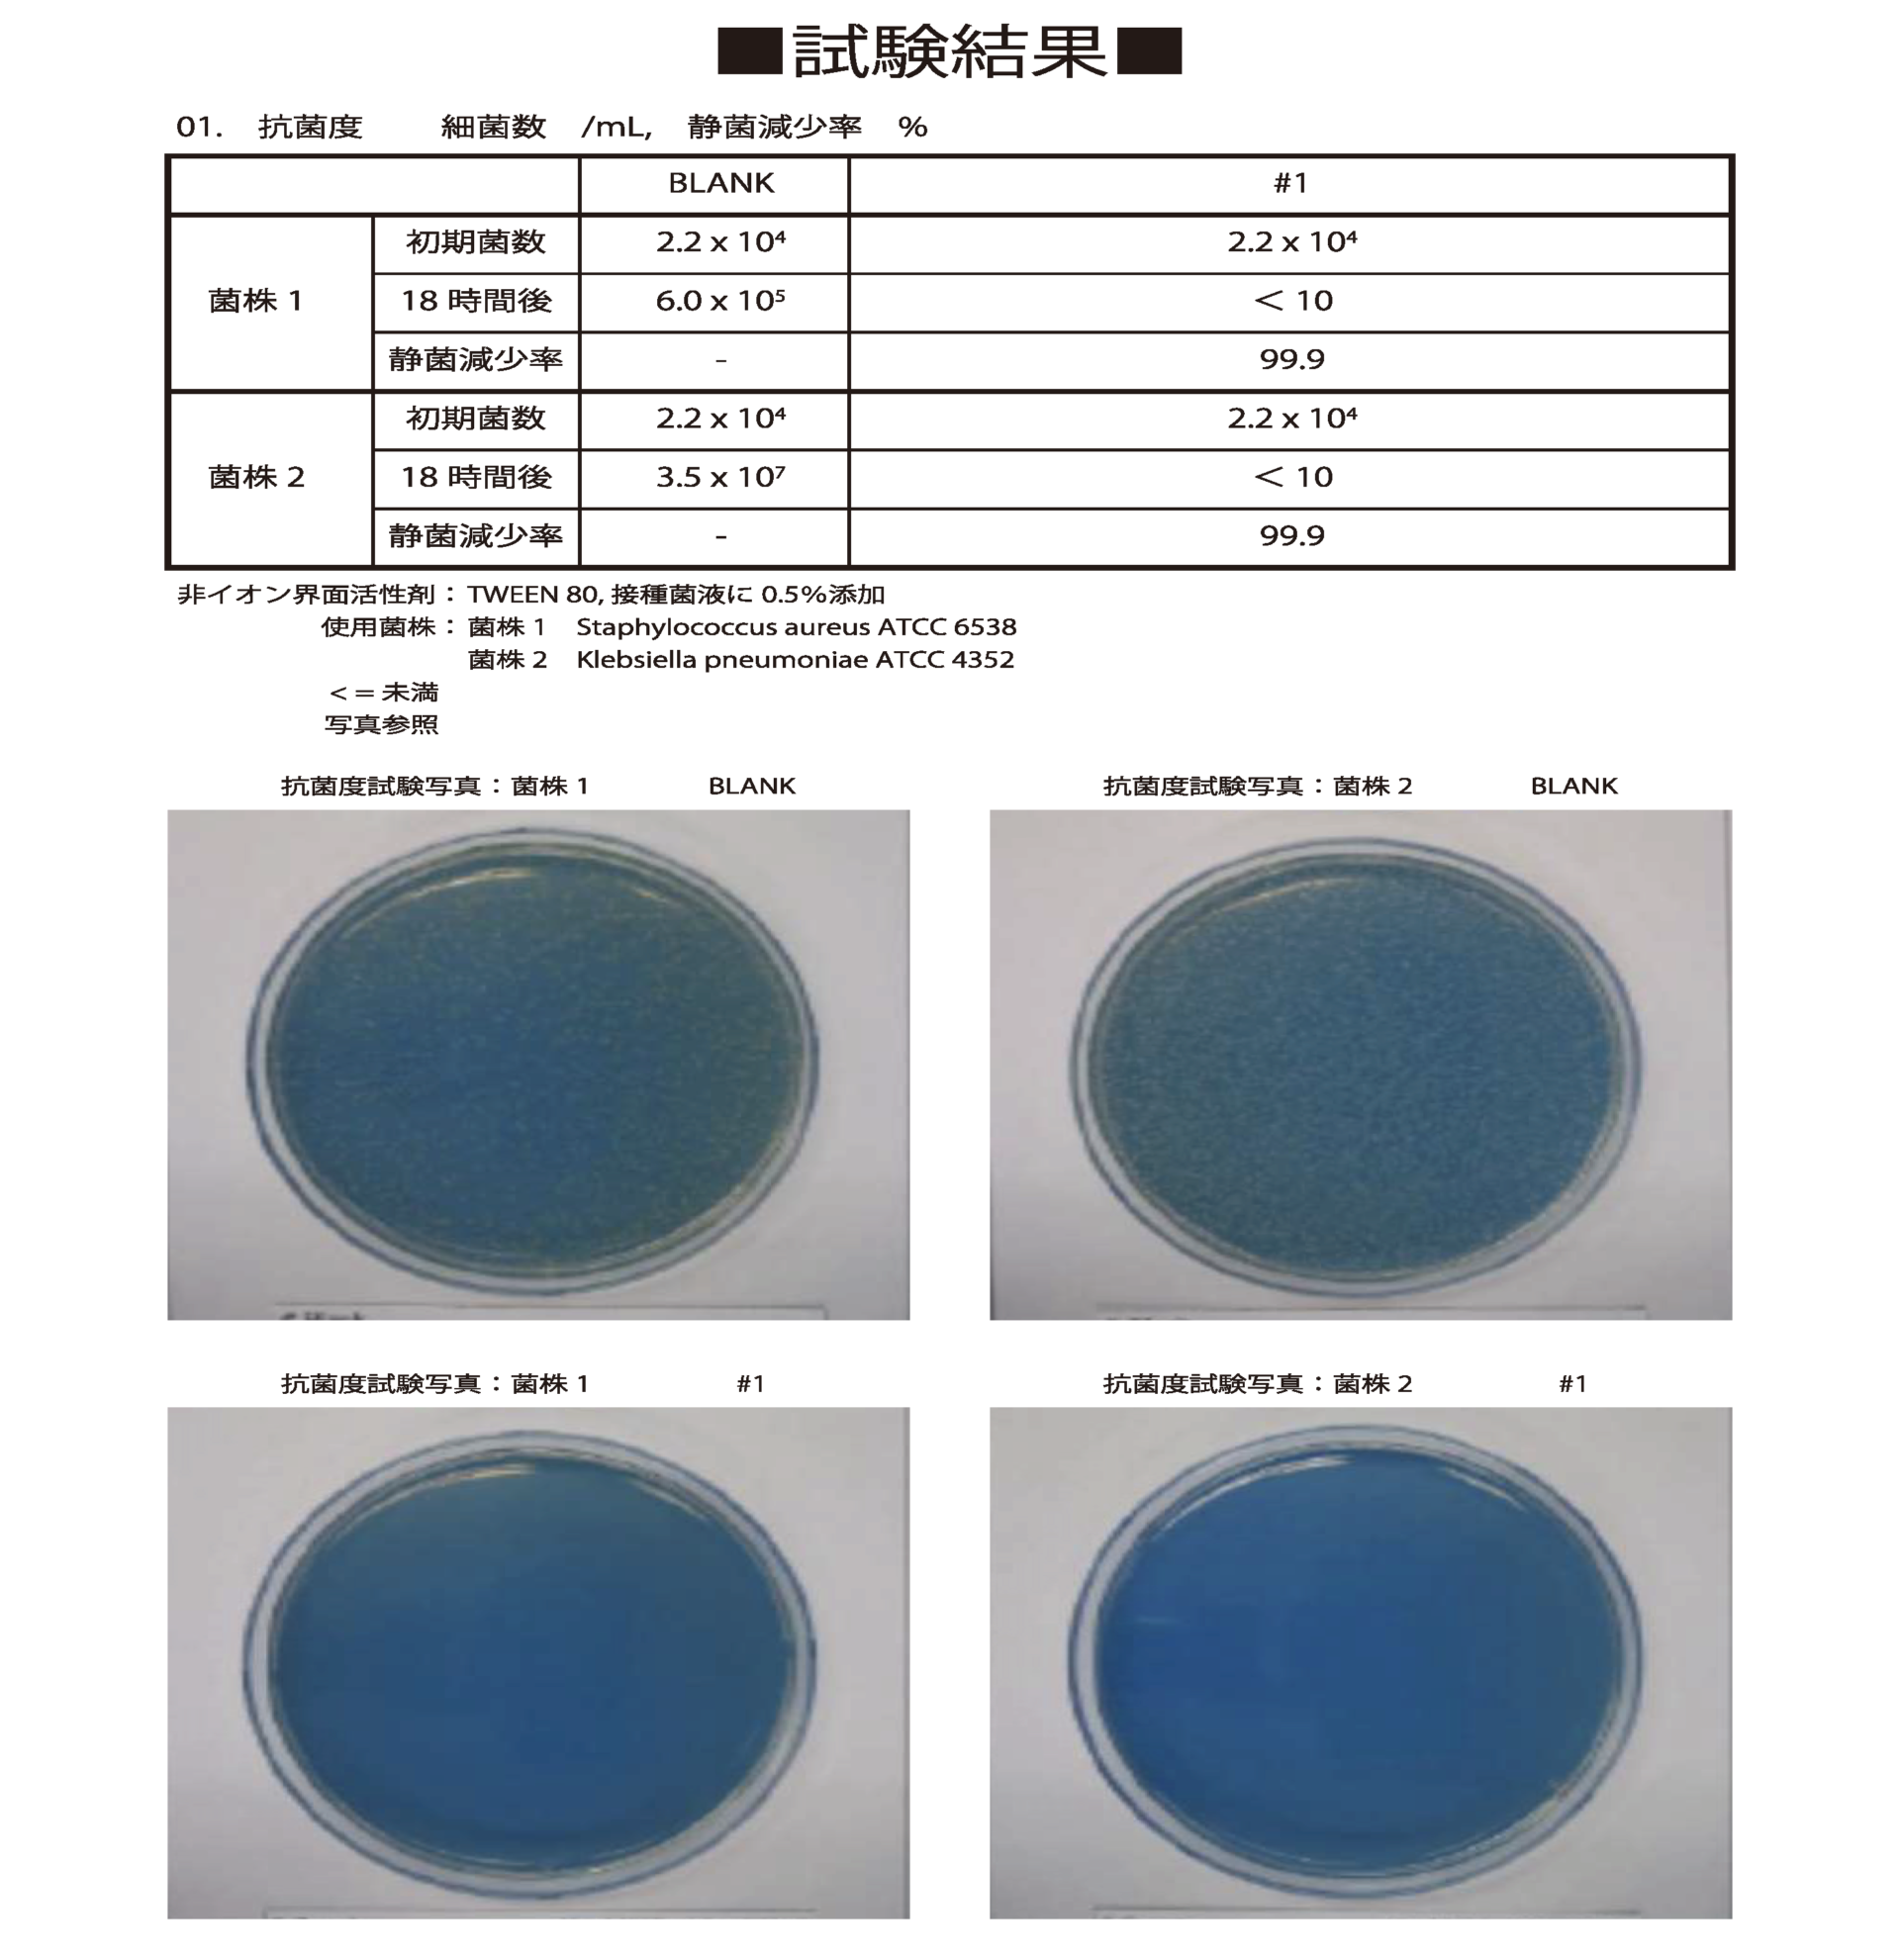

車内の空気を安全清潔に
空気中には目に見えないゴミや有害物質等が多く存在しています。
これらは髪の毛の直径よりも小さいものが多く、純正のエアコンフィルターでは完全に除去することは不可能です。
3つの効果を発揮する「SAP TRIPLE GUARD SYSTEM」を採用した
「GruppeM CABIN FILTER(キャビンフィルター)」
純正よりもはるかに優れた集塵性能と、純正には無い除菌・消臭機能で
車内をクリーンにし、より快適な空間を創造します。



高い濾過性能を誇るSEMI-HEPAフィルター
主要濾材は0.3μm 以上の塵埃を95%以上捕集することができるSEMI-HEPAフィルターを採用。髪の毛の30分の1サイズの埃や細菌を確実にキャッチします。濾材をプリーツ状に折り込むことで吸入面積を確保し、絶対流量を確保。圧損によるモーターへの負担を最小限に抑えています。手術室・ICU・新生児室・回復室など清浄空間が要求されるクリーン施設・ 機器にも多く採用されている高性能濾材です。

ホコリ、花粉、ウイルス飛沫などをシャットアウト
埃や花粉などよりもさらに細かい0.3μmサイズの有害物質を95%まで除去することが可能です。

濾過性能テスト

ハニカム構造の活性炭層
活性炭はもともと浄水場などで濾材として用いられています。活性炭の特徴である高い吸着効率を生かし、カビなどに含まれる臭気成分や有機物を除去して浄化。繰り返し通過する空気を脱臭し続けます。この活性炭を含んだ帯状の素材をハニカム構造の特殊層とすることで有効表面積を確保しながら圧損を抑制し、モーターへの過度の負担を与えない設計としています。無光触媒の消臭機能との相乗効果により、エアコン内のカビ臭や車内の臭いを強力に除去します。

ホルムアルデヒド、アンモニアなどに効果を発揮
シックハウス症候群などの健康被害や発がん性物質とも言われている有機化合物の一種「ホルムアルデヒド」をはじめ「アンモニア」「酢酸」「トルエン」「アセトアルデヒド」といった臭気の強いガス類に対し、活性炭の高い吸着効率により、平均90%以上の脱臭が可能です。

暗くても効果を発揮し続ける無光触媒加工
SEMI-HEPAフィルター表面には光を全く必要としない、暗所においても消臭・抗菌・抗ウイルス・防汚・防カビなど様々な効果効能を発揮する機能性コーティングを施してあります。取り付けた状態でも触媒反応がおき、フィルターに付着したゴミや細菌・ウイルスなどに対し、メインテナンスを行わなくても長期間効果を発揮します。

黄色ブドウ球菌や肺炎桿菌(かんきん)を99.9 %滅菌
食中毒の原因となる黄色ブドウ球菌や様々な感染症を引き起こす肺炎桿菌を99.9%の滅菌率を実現しています。